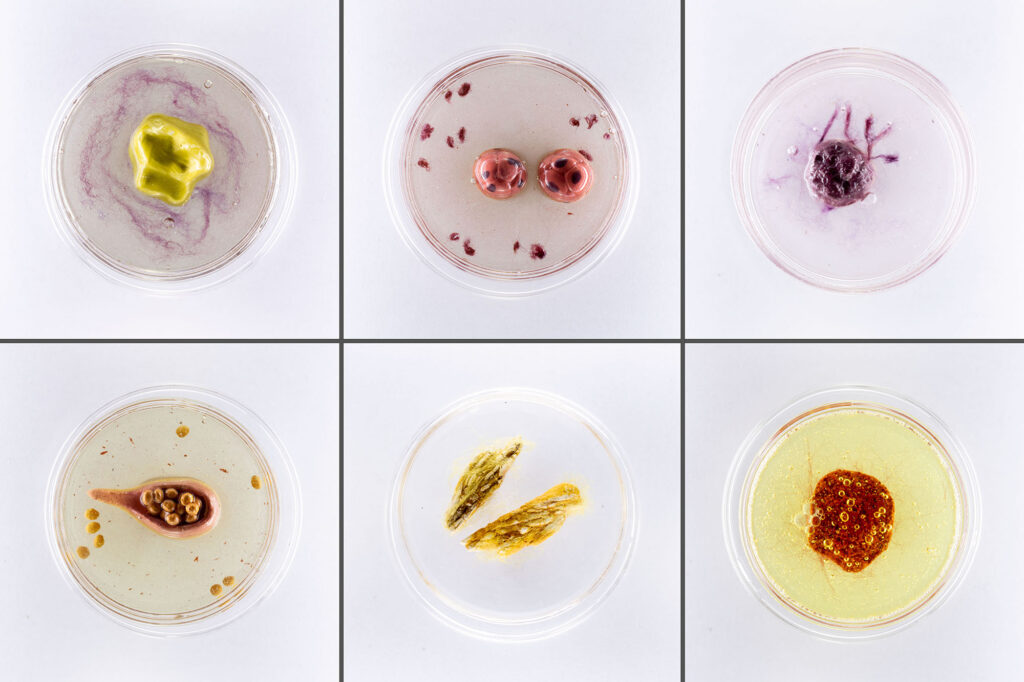
Six petri dishes seen from above with colorful ceramic cells and mixed-media dye within.

Please note that we acknowledge both identity first and person first framing of disability identity. When we use the phrase “disabled artists,” we intend to align with the Social Model of Disability understanding that people are disabled by environmental and societal barriers.
Arts Midwest is thrilled to announce the winners of the 2024 Midwest Award for Artists with Disabilities. This award, designed to support accessibility in the arts and celebrate the exceptional work of disabled Midwestern visual artists, has received an incredible response from the artistic community. Over 300 artists applied to receive funds, and a panel of seven reviewers narrowed the pool to nine finalists from across the Midwest.
We are delighted to recognize the creativity and dedication of nine incredible artists who have been making a significant impact in the field:
- Serena Elston (Chicago, Illinois)
- Emily Wilson Gillespie (Bloomington, Indiana)
- Lindsey Row-Heyveld (Decorah, Iowa)
- Charlie Reynolds (Dexter, Michigan)
- Virginia Townsend (South Saint Paul, Minnesota)
- Danielle Billing (Enderlin, North Dakota)
- Heather Moore (Columbus, Ohio)
- Mark Hansen (Sioux Falls, South Dakota)
- Carly “Car” Reigger (Madison, Wisconsin)
As part of this award, each recipient will receive $3,000 to support their artistic journey, with no restrictions on how they choose to use this funding.
“The best part of this process, without a doubt, has been getting to see all the incredible artwork submitted alongside the applications,” says John Kaiser, Grants Manager & Accessibility Co-coordinator at Arts Midwest. “I don’t envy the panels job of selecting just one artists per state when there are so many worthy of recognition.”
Established in 2022, the Midwest Award for Artists with Disabilities is supported by the James Edward Scherbarth and Paul Francis Mosley Giving Fund. The award was created in honor of the late James Edward Scherbarth, an award-winning visual artist, visual arts teacher, and advocate of arts access who lived and worked in Minnesota. Jim believed that creativity lives in everyone, and he dedicated his career to helping people express themselves through the visual arts.
Join us in celebrating the creativity our awardees bring to the Midwest, and explore some of their works below:
Serena Elston (Chicago, Illinois)
I am a transdisciplinary sculptor contemplating the body and its relationship to structures of power. My research-based practice explores ecology, posthumanism, disability, and embodiment through a post-colonial lens. At its core, my practice asks if an institution has the power to disable a body, does the body have the power to disable an institution? Grappling with the identity of disability, I depict figures in various stages of decomposition and incompleteness. My work seeks to make visible the precarious materiality of structures to reveal them as inherently temporal.
Institutions are not independent from the mortal bodies that serve them. In this way individual acts of maintenance become political and ‘disability’, rather than ‘wellbeing’, is relegated as a colonial determination of labor potential that is designed to diminish our humanity in institutional settings. My art reflects on the fragility of the bodies we inhabit and rely upon and the porosity between the two.





Emily Wilson Gillespie (Bloomington, Indiana)
My paintings are a composite of memory, observation, and imagination, pulling inspiration from photographs, childhood recollections, and recent studies. The interaction between memory and present reality creates a space for both discord and harmony in my work.
Daydreaming and escapism are both equally rooted in my neurodivergence and my artistic practice. Abstraction allows me to utilize the inspiration from my source imagery and play up emotions through color and shape. While the resulting landscape is often inspired by the rural Midwest, it may not necessarily share a resemblance. I love this – that my landscapes are open to the viewer’s own interpretation.
It is my goal to continue to create work that allows the viewer to escape within it. The larger work I have created in the past year feels almost immersive, and I would like to continue making work on a larger scale. Additionally, I hope to continue to find and practice a holistic balance to care for myself so that I can manage the physical demands of painting and allow my body to recover accordingly.





Lindsey Row-Heyveld (Decorah, Iowa)
I am a calligrapher; text is as vital a medium to me as paint or ink. I’m interested in both the aesthetic qualities of words and their textual meanings, and I intend that the way words are presented visually and the meaning they contain speak with one voice. I am influenced by the palette and patterns of Amish and Mennonite quilts; by the geography of the Great Plains, where I grew up, and the Driftless Region of the upper Midwest, where I live now; and by historic folk lettering. As a disabled artist, I find in calligraphy a place where my neurodivergence can flourish. I see myself as an interpreter: I take a work of art in one medium (typically poetry) and translate it into another. My purpose is to create greater access to the text, allowing viewers/readers to experience it differently than they would printed on a white page. I want to open the text, break it apart, and reveal its facets. But more than that, like a singer covering another songwriter’s work, I want to express the text and make it mine.





Charlie Reynolds (Dexter, Michigan)
When I was 19, I enlisted in the United States Navy. The things I did in those four years is something that I have continually tried to grapple with through the use of alcohol, therapy, and eventually art. My perspective as a privileged citizen coming from a global superpower shifted as I began to visit foreign ports, realizing how other people felt about our country and our military. My previous ideas of “good guys”, “bad guys”, and justifiable wars began to feel very childish.
What I find both compelling and necessary is the examination of the military culture I so easily subscribed to through the dissection of the military artifacts and symbols I worshiped. Weaving allows me to meditate and immortalize these artifacts that I’ve saved from my time in the Navy. Each weaving takes about 5-6 hours, and I can really ponder every line or thread. Did I really read my contract before I signed it? Why did I save what I saved? Is it precious or was I just doing what I was told? As I contemplate the military’s current role in my life, these artifacts and symbols haunt me.
My interest in fiber is directly related to my struggle with gender identity. When I was a child, my GG and my grandma taught me how to crochet, knit, cook and other traditionally feminine pastimes. I hated these useful hobbies that would make me a better wife. I wanted to be rough, hard, and dirty. Masculine.
Now that I can live as a man and I’m comfortable with my masculinity, I find myself drawn to the softer mediums I neglected in the past. Maybe the only way to talk about hard topics is through soft fabrics. My life in the Navy was all steel, missiles, guns, and patriarchy. I think it makes sense then to dissect it through traditionally feminine craft.



Virginia Townsend (South Saint Paul, Minnesota)
My work is disability- and femme-centric non-objective abstract art. My goals are to explore my experiences of mental health unit hospitalizations, being “high need” according to Hennepin County, and navigating group homes and other facilities as a woman with trauma. My goal is to challenge the idea that topics related to women need to be represented by literal depictions of femme bodies, often sexualized. Using non-representational scenes I level uneven power dynamics between those with disability and those without. My goal is for no one to have an advantage when viewing my work, so viewers of class or economic status differences can interpret the images in equally meaningful ways. This helps people less defensive and more open-minded when talking about historically stigmatized subjects, like mental illness and behavioral disorders. My work expresses these goals by setting the scene for novel and solution-focused conversations. The way I paint is using repeating patterns, neon colors, and weaving layers to demonstrate immediacy and complexity higher need disabled people face with their services and the difficulty large systems have providing truly person-centered care.





Danielle “Elle” Billing (Enderlin, North Dakota)
I am an artist, caregiver, and educator. Making art is how I filter a continuous stream of information, through the particular lens of my queer disabled bodymind.
Currently, I am interested in exploring concepts of memory, gender, and identity. I am reconstructing the western feminine literary experience through mixed media with a focus on vintage texts and artifacts. I create paintings through an iterative process I call Spiritual Archaeology. I layer my personal experiences between literary influences and contemporary media, using mixed media and bold marks. My influences stack up on a common theme, and as I scrape back what I have layered, I am able to excavate a singular truth about my Self and my place in the world.
Through each process iteration, I produce a cohesive body of work of around 12 pieces. The materials I am most excited by are vintage books, acrylic paint, all manner of pastels, and compelling songwriter-vocalists. I am deeply drawn to surrealism, artistic tension, the multiverse, and alternate timelines. In the studio you will find me deconstructing old books, making my own collage paper, and infusing my work with the power of story.





Heather Moore (Columbus, Ohio)

I am a Columbus, Ohio based artist with a passion for living history and public art, working in a variety of mediums with a focus on Slavic folk arts such as pysanky, embroidery, and the khokhloma painting technique. My mission is to document and preserve the lore, practice, and craft of my ancestors in art, writing, and education that incorporates the evolution of these practices within the diaspora of the Carpatho-Rusyn people who live in Ohio and the Midwest region today.
My art is focused on using ancient tools and techniques to create work inspired by a modern urban life. Pysanky are made not by painting but with melted wax applied with a tool called a kistka and a resist dye technique that has remained virtually unchanged since pagan times. This deep respect for the past has led me to the exploration of intergenerational trauma, oral family histories, and bringing a brighter, more compassionate light to family and community history.
Mark Hansen (Sioux Falls, South Dakota)
Mark Hansen has always been an artist at heart. For most of his career, he worked as a graphic arts director in the advertising industry, creating eye-catching designs and logos for various clients. He also enjoyed drawing with pencil as a hobby, producing many pieces that his family and friends admired.
However, three years ago, Mark’s life changed dramatically when he suffered a massive stroke that left him with minimal verbal skills and unable to use his right hand, which was his dominant hand. Drawing was an important part of Mark’s life, and he did not want to give up on his passion. He decided to teach himself how to use his left hand to draw, and to challenge himself further, he switched from pencil to colored pencils, adding more vibrancy and depth to his artwork.
His works demonstrate his resilience, creativity, and talent as an artist, and inspire others to overcome their own obstacles and pursue their dreams.



Carly “Car” Reigger (Madison, Wisconsin)
My work is a direct response to my life with Ehlers Danlos Syndrome (EDS), an inherited disorder that causes pain in the connective tissues throughout the body. My experience is grounded in many hospitals stays, surgeries, and being constantly unsure of the cause of pain in my body. My work documents, preserves, and expresses my inner turmoil and disability, as it is not always visible to others. Many people have denied me care, made judgements or decisions based on my physical appearance, therefore, I create work that documents my internal state as an undeniable physical expression of my pain. These situations are common among people with disabilities, so I aim to bring this important topic to light through honoring true representations of my own disabled experience. I use various materials to convey both the tenuous state of an ill body and the way it is perceived. With many inaccurate and ableist historical and societal interpretations of the disabled body, I choose to speak about my own experience through the disabled lens as a reclamation of my identity.

About the Midwest Award For Artists With Disabilities
The Midwest Award for Artists with Disabilities supports accessibility in the arts and celebrates the work of disabled Midwestern visual artists.
From 2023–2025, the award will recognize 27 individuals (9 per year) in the Arts Midwest region.
Applications will open again in spring 2025. Learn more and stay tuned by visiting the award homepage.

